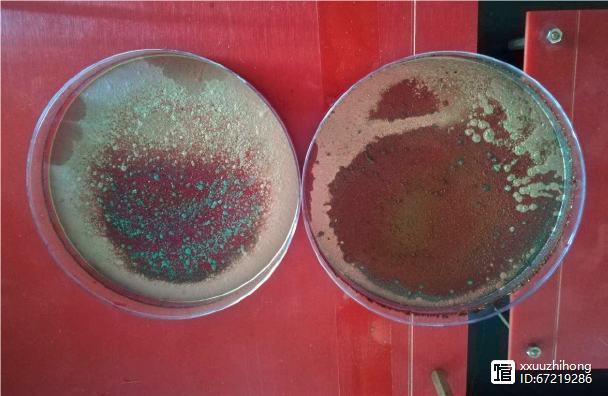

技術研發
聯系我們
地址:北京市海淀區阜外亮甲店1號恩濟西園10號樓
郵編:100097
電話:010-88593861
傳真:010-88593865
添加時間:2022-07-14 21:40
| 羅丹明B溶液的濃度 | 飽和 |
| 培養皿直徑(對照組與實驗組相同 | 90mm |
| 培養皿高度(對照組與實驗組相同) | 13mm |
| 溶液體積 | 20ml |
| 標量波輸出頻率 | 3KHz |
| 標量波輸出波形 | 方波 |
| 實驗時間 | 4-7天(直到水分完全蒸發) |
| 標量波發生器工作模式 | 右旋 |

由此實驗可以初步得出結論,被標量波處理的溶液結晶后形成的晶體顆粒明顯大于對照組結晶后形成的晶體顆粒。
標量波水處理的優越性
與當前各種非標量波方式的普通電磁場相比,標量波攜帶的電磁能量場具有很多的優越性,將其用于工業水處理可能會獲得如下比較優勢:
1.???????標量波的特性之一是不隨時空發生衰減,因此它承載的交變電磁信號將不會出現明顯衰減,強度保持穩定。
2.???????工業水處理設備的安裝和使用絕大部分從輸水管道著手,并且有些客戶特殊要求還不能接觸水體或者切割管道,于是可以利用標量波超強的穿透能力將處理信號穿過管道設備傳輸進水體中,可以做到信號無障礙靶向作用于水中所有物質。
3.???????標量波作為載波,調制波可以根據水中物質的具體情況進行定制,理論上可以針對水中的物質成分和含量做出專有信號的水處理設備,一對一解決問題。
標量波水處理技術應用前景展望
標量波應用于工業水處理的意義重大,體現在
1.???????可以大幅度減量化學藥劑的使用。目前化學藥劑仍然是主流手段的水處理方法。如果使用標量波的強大穿透能力,避開了金屬管道和設備對普通電磁場的阻礙和吸收,那么這一物理式的綠色環保水處理方法將會變得非常有趣而又富有經濟效益。在水質比較好的地域,甚至完全可以取消化學加藥,代之以有效的純物理方法,真正實現零污染廢水排放。
2.???????可以大量節約水資源。標量波攜帶的能量場可以提高水體中對結垢離子的容忍度,從而在工業循環冷卻水系統的水處理當中適當提高濃縮倍率,達到很可觀的節水效益。有數據表明工業循環冷卻水占據了約70%以上的工業生產用水比例,為了保護冷卻設備不結垢,不少使用單位的系統維持在較低的濃縮倍率(低于3.5)下運行,大量的地表水、自來水等潔凈水被迫以廢水形式排放掉,實屬水資源管理中的無奈之舉。
3.???????抑制細菌和藻類的繁殖和生長。細菌和藻類的存在會降低各種水質標準。化學藥劑的使用不可能面面俱到,大型的工業用水管網非常復雜。水管的某些彎頭、閥門,以及末端的局部死角往往成為管網中最脆弱的部位。由流體力學的基本知識得出在水管中心部位,水流速度最大,越接近管壁水流速度越慢。細菌一般是附著在管道內表面,甚至藏在管道內表面的污垢里面,繁殖生長,形成各類微生物,它們的分泌物及死尸又進一步形成酸性腐蝕物質,造成垢下腐蝕。
4.???????降低使用單位設備維護成本。由于設備結垢而進行頻繁的清洗作業,除了耗費大量的人力財力,還會或多或少對設備施加了不應有的潛在腐蝕風險。清洗過程中使用的酸性化學藥劑對設備具有腐蝕性,加上如果操作上存在問題,則會帶來更大風險,工程中有把客戶設備洗漏了的也不是沒有。
5.???????很適合民用生活用水。無論是自來水飲用水,還是洗浴用熱水管網,都不允許任意添加各種化學藥劑。理論上說做到“零添加”是最理想的。但是在現實應用當中,無論是普通的自來水管網,還是市政熱水管網,都會存在殺菌阻垢的訴求。
?
參考文獻
[1] Tesla N. Apparatus for transmission of electrical energy. US Patent No.645576,New York, 1900
[2] Meyl K. Scalar Waves: Theory and Experiments, Journal of Scientific Exploration, vol.15, no.2, pp 199-205,2001
[3] Mills H. Tesla's scalar fields still beaming on [J]. Pure Energy Systems News, Apr. 2011: 1-6
[4] Zohuri B.Scalar Wave Driven Energy Applications, Springer, 2018
[5] Kernbach S. On metrology of systems operating with high-penetrating emission, International Journal of Unconventional Science, 1(2), pp 76-91, 2013
[6] Victor Shkatov, Vitaliy Zamsha. Torsion field and interstellar communication, 2015
[7]?李嗣涔.撓場的科學,三采文化出版,2020
[8]?黃志洵.?波科學與超光速物理,國防工業出版社,2014
[9] 伍平,王勃,王曉東.交變電磁場在晶體生長與凝固方面的應用,中國材料進展,2017年12月
[10] Metan V, Eigenfeld K. European Physical Journal – Special Topics, 2013 (1):139-150
[11]?玻恩?M.,黃昆.?晶格動力學理論,北京大學出版社,1989
[12]?高鵬.撓場干預下的非正常結晶過程,2018
地址:北京市海淀區阜外亮甲店1號恩濟西園1號樓213室電話:010-88593512
Copyright © 2020-2025 微浪量子技術發展(北京)有限公司 版權所有 ICP備案編號:京ICP備2021004822號-2